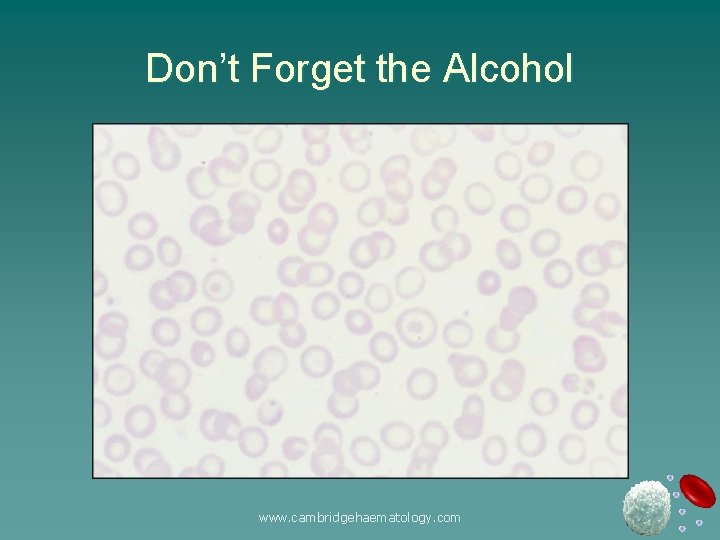
Don’t Forget the Alcohol www. cambridgehaematology. com
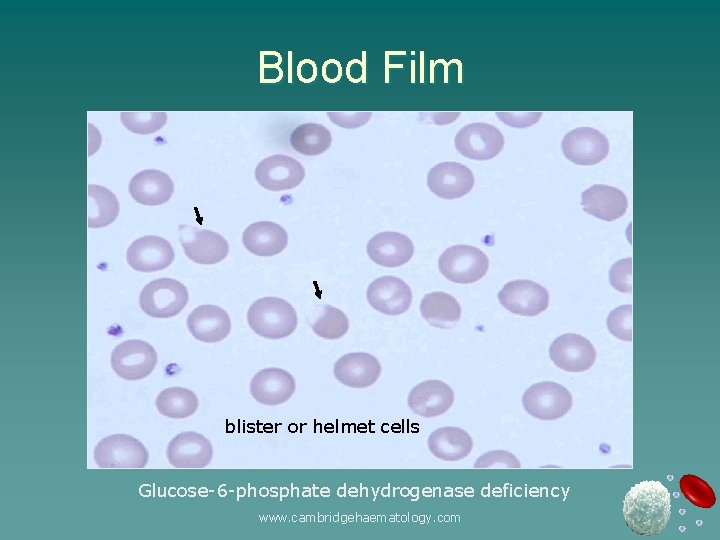
Blood Film blister or helmet cells Glucose-6 -phosphate dehydrogenase deficiency www. cambridgehaematology. com

Haematology in Primary Care The Full Blood Count

Haematology in Primary Care: The Full Blood Count Charles Crawley George Follows Cambridge Haematology Partners www. cambridgehaematology. com

The FBC www. cambridgehaematology. com

Haemoglobin u Low haemoglobin defines anaemia – Males 13 -18 g/l – Females 11. 5 -16 g/l – Variations: u Children – Neonates – 14 -24 g/l – 2 months – 8. 9 -13. 2 g/l – 9 -12 ys - 11. 5 -15. 4 g/l u Pregnancy – 3 rd Trimester – 9. 8 -13. 7 g/l u Age – 5 -7 th decade – falls in men rises in women u Exercise – Increases Hb u Altitude u Smoking www. cambridgehaematology. com

MCV u Mean Cell Volume: average size of RBC – Normal adult : 76 (80) - 100 f. L u MCV < 76 f. L (microcytic) u MCV > 100 f. L (macrocytic) u MCV 80 - 100 f. L (normocytic) www. cambridgehaematology. com

Practical Classification of Anaemia Microcytic (<76 f. L) Iron deficiency Thalassaemia Haemoglobinopathies Anaemia of chronic disease Lead Hyperthyroidism Normocytic Blood loss Haemolytic - RBC membrane - Enzyme defects - Extrinsic Stem cell defects Macrocytic (>100) Megaloblastic Excess alcohol Hypothyroid Liver disease Reticulocytosis Drug therapy Marrow failure Reticulocyte count: In the investigation of anaemia • Reduced: Failure of erythropoiesis • Increased: Appropriate BM erythroid response www. cambridgehaematology. com

35 year Male u Hx: Lethargy, SOB u Sx: Pale u FBC: Hb 6. 4 g/d. L MCV 71 f. L RDW 0. 19 WCC 5. 2 Platelets 375 u Film: Severe hypochromasia and microcytosis www. cambridgehaematology. com

Commonest Causes Iron Deficiency 1 – 5 yr 5 – 15 yr Female Male Nutrition Increased utilisation/ growth 15 – 40 yr Menstruation Pregnancy > 40 yr Increased utilisation/ growth Coeliac disease (Malabsorption) Gastrointestinal Blood loss www. cambridgehaematology. com

Blood Film www. cambridgehaematology. com

Differential Diagnosis u Causes of microcytic hypochromic anaemia – Iron deficiency u Blood loss u Malabsorption - Coeliac disease; gastrectomy u Increased utilisation - parasites u Dietary deficiency - rare – Haemoglobinopathy – Anaemia of chronic disease www. cambridgehaematology. com

Fe Deficiency vs Anaemia of Chronic Disease Variable Serum Iron Transferrin Fe deficiency Transferrin Saturation Ferritin CRP or Normal GIT studies: endoscopy etc www. cambridgehaematology. com Chronic disease or Normal or normal

26 year Female u Hx: u FBC: u Film: Antenatal visit; First trimester Hb 11. 0 g/d. L MCV 73 f. L MCH 27 pg RDW 0. 14 WCC 8. 5 x 109/L Platelets 164 x 109/L Microcytic RBC www. cambridgehaematology. com

Fe Deficiency vs Hbinopathy u Check iron status: Ferritin u Family history / ethnicity: – Thalassaemia / haemoglobinopathy – Need to determine risk to fetus of severe thalassaemic syndrome (in 1 st rimester): u Homozygous thalassaemia (α or β) u Homozygous Hb S (sickle cell disease) u Severe compound heterozygous states – E. g. : Hb. S/β; Hb. E/β; Hb. SC – Determine need to check partner www. cambridgehaematology. com

Red Cell Distribution Width (RDW) u u The degree of variation in size of RBC: N <14 Increased RDW corresponds with anisocytosis: – Iron deficiency (increased RDW is the earliest lab feature: anisocytosis precedes the anaemia) – Megaloblastic anaemia (can be very high >20) – Anaemia with bone marrow erythroid response (i. e. reticulocytosis) u RDW useful in DDx of microcytic anaemias. – – Most cases of iron deficiency: raised RDW thalassaemia trait: normal RDW www. cambridgehaematology. com

MCH u Mean Cell Haemoglobin (27 -32 pg) – The mean haemoglobin per red blood cell u u MCH usually rises or falls as the MCV is increased or decreased. MCH < 25 pg used as a guide to the presence of thalassaemia or haemoglobinopathy. – MCH usually markedly reduced in thalassaemia (e. g. beta thalassaemia trait MCH 19 pg) www. cambridgehaematology. com

Haemoglobin Studies 1. Normal adult 2. HPFH (heterozygote) 3. Hb S--HPFH 4. Hb C--HPFH 5. Normal newborn A/F/S/C control www. cambridgehaematology. com

73 year male u Hx: Tiredness u FBC: u Film: Hb 4. 0 g/d. L MCV 102 f. L RDW 0. 24 WCC / Plt Normal Macrocytes, fragmented red cells, occasional NRBC www. cambridgehaematology. com

Blood Film 73 yr old male www. cambridgehaematology. com

Severe Macrocytic Anaemia u Megaloblastic anaemia u Liver disease: end-stage failure u Red cell aplasia: – Parvovirus; thymoma, other malignancy u Bone marrow failure or infiltration: – Myelodysplasi – Multiple myeloma www. cambridgehaematology. com

Investigations 1. 2. Serum vitamin B 12 Red cell folate (serum folate) Reticulocyte count (BM 3. 4. 5. Liver function Parvovirus serology Bone marrow examination erythroid function) www. cambridgehaematology. com
Don’t Forget the Alcohol www. cambridgehaematology. com

Other Causes of Macrocytic Anaemia Severe liver disease u Excess alcohol u Haemorrhage / haemolysis: reticulocytosis u Drug therapy: esp. cytotoxics u Hypothyroidism u Myelodysplasia u Marrow infiltration u – Bone marrow examination may be indicated www. cambridgehaematology. com

Myelodysplasia (MDS) u Clonal disorder u Ineffective haematopoiesis u Incidence increases with age – Age 50 yrs - 1 per 100, 000 – Age 70 yrs – 25 per 100, 000 u RBC, WCC, and platelets affected www. cambridgehaematology. com

Myelodysplasia Bone Marrow www. cambridgehaematology. com Peripheral Blood

Myelodysplasia u Prognosis u Survival u Management – Number of cytopenias – BM Blast percentage – Cytogenetics – Age – Varies 11. 7 yrs – 0. 4 yrs – Supportive – Stem cell transplantation – New drugs www. cambridgehaematology. com

Normocytic Anaemia Multiple aetiologies u Primary marrow production defect u – Myelodysplasia – Marrow infiltration – Haematinic deficiencies u Reduced red cell survival – Blood loss – Intrinsic defects (eg. Enzyme; membrane) – Extrinsic defects (eg. Plasma problems) www. cambridgehaematology. com

Approach to Normocytic Anaemia u History: – Acute blood loss ; jaundice; dark urine u Exclude treatable causes: – Check ferritin, folate, vitamin B 12 – Renal and hepatic function – Acute phase reactants u Consider haemolysis The blood film may have the answer ! www. cambridgehaematology. com

78 year male u Hx: Chest pain u PMHx: Myocardial infarct u FBC: Hb 7. 2 g/d. L MCV 97 f. L WCC 4. 5 x 109/L Platelets 320 x 109/L Reticulocytes: 320 (10 -100) www. cambridgehaematology. com

Blood Film www. cambridgehaematology. com

Blood Film u RBC: Spherocytes Polychromasia Nucleated red cells Spherocytic haemolytic anaemia: Auto-immune haemolytic anaemia Hereditary spherocytosis www. cambridgehaematology. com

Other Investigations u Biochemistry: – Bilirubin – Other LFT – LDH – Haptoglobin u 100 μmol/L (<20) Normal 1, 500 U/L (120 -240) <0. 1 Haematology: – Reticulocyte count – Direct anti-globulin (Coombs) test: Positive u Enzymes, u Hereditary spherocytosis screen www. cambridgehaematology. com

Haemolytic Anaemia u Primary Red Cell Problem: u Secondary Red Cell Destruction – Red cell membrane: Hereditary spherocytosis – Enzyme defect: G 6 PD deficiency – Haemoglobin defect: thalassaemia – Abnormal red cells: dyserythropoiesis (MDS) – Autoimmune – Severe hepatic dysfunction – Red cell fragmentation: DIC; HUS; TTP – Infections: malaria; clostridium www. cambridgehaematology. com
Blood Film blister or helmet cells Glucose-6 -phosphate dehydrogenase deficiency www. cambridgehaematology. com

Normocytic Anaemia u Blood film may have the answer: – Normal red cell morphology – Dimorphic (high RDW): 2 x RBC populations – Marked anisocytosis: marrow dysfunction/MDS – Is there polychromasia? u Yes: Anaemia with marrow response u No: Impaired marrow response – Anaemia of Chronic Disease – BM failure – Red cell aplasia : Parvovirus; aplastic anaemia www. cambridgehaematology. com

Polycythaemia Pseudopolycythaemia u Primary u – Polycythemia vera u Secondary – Hypoxia u Altitude u Cardiac/Pulmonary u Cirrhosis disease u Abnormal Haemoglobins u Chronic CO exposure – Inappropriate erythropoietin u Renal lesions u Tumours www. cambridgehaematology. com u Drug

Clinical Features u Hyperviscosity – – – u Headaches Blurred vision Breathlessness Confusion (Plethora) Thrombosis – Venous + arterial – Bleeding u Other – Pruritis – Gout www. cambridgehaematology. com

Polycythaemia investigations u FBC + Film u CXR u Cardiac assessment u Red Cell mass u Blood gasses u Major advance – JAK 2 mutation screens www. cambridgehaematology. com

JAK 2 Presence of the V 617 F mutation indicates that the patient has an acquired, clonal hematological disorder and not a reactive or secondary process. u Absence of the JAK 2 V 617 F mutation does not exclude a MPD as up to 50% of patients with ET and IMF will have wildtype JAK 2. u The V 617 F mutation does not help in subclassifying the type of MPD of a given patient u www. cambridgehaematology. com

Pathogenesis: Deregulated Tyrosine Kinases in MPD CML BCR-ABL CMML TEL-PDGFRB CEL FIP 1 L 1 -PDGFRA SM KIT D 816 V PV JAK 2 V 617 F ET JAK 2 V 617 F IMF JAK 2 V 617 F www. cambridgehaematology. com

Questions so far? www. cambridgehaematology. com

Platelets u Too many (thrombocytosis) u Too few (thrombocytopenia) u Dysfunctional – When should we worry? www. cambridgehaematology. com

Thrombocytosis u> 450 x 109/l u Causes – Reactive (almost anything!) u Common – bleeding, infection, malignancy u Tend to be less than 1000 x 109/l – Primary bone marrow disorder u Myeloproliferative disorders (up to 3000+) (essential thrombocythaemia, myelofibrosis, polycythaemia, chronic myeloid leukaemia) www. cambridgehaematology. com

Thrombocytosis u History, examination should guide investigations and referrals u Should the patient be on aspirin? – Only firm evidence is MPDs – Reactive often given if > 1000, but little evidence for this www. cambridgehaematology. com

Thrombocytosis u Essential Thrombocythaemia (ET) – Long term management balancing thrombotic vs bleeding risk – Aspirin for intermediate risk – Cytoreduction + aspirin for higher risk (beware the pseudohyperkalaemia!!) www. cambridgehaematology. com

Thrombocytopenia u Is it real? ? ? – Poor sample – Clumped in EDTA – blood film **If at all possible confirm with a repeat sample www. cambridgehaematology. com

Thrombocytopenia Pancytopenia vs Isolated low platelets u Pancytopenia – – always serious (marrow failure) u Isolated – may be relatively unimportant www. cambridgehaematology. com

Thrombocytopenia u Decreased production – Rare in isolation – Viral infections u Increased consumption – Autoimmune – ITP – Drugs – Pregnancy – Large spleen / portal hypertension – Infections (HIV) – RARE but serious TTP – HUS - DIC www. cambridgehaematology. com

Thrombocytopenia u Investigations suspicion depend on clinical – Platelet volume may be helpful (small - think marrow) u <8. 0 and >10. 5 – BM often not required www. cambridgehaematology. com

Thrombocytopenia (not joint bleeds!) www. cambridgehaematology. com

Thrombocytopenia u How real is the bleeding risk? – Cause of low platelets – Wet vs dry purpura – Platelet transfusions often not useful www. cambridgehaematology. com

ITP – a few useful reminders u Children – Acute, post viral, – spontaneous resolution (often no therapy) u Adult – More insidious onset – Chronic = common – Many (not all!) cases do require treatment – Steroids – splenectomy – Novel therapies www. cambridgehaematology. com

Platelet Dysfunction u Range of rare inherited causes – Family history – Refer the child that bleeds abnormally! u Don’t forget the acquired dysfunction – Renal failure – Liver disease – ASPIRIN www. cambridgehaematology. com

Questions and break! www. cambridgehaematology. com

White Cells www. cambridgehaematology. com

White Cells www. cambridgehaematology. com

White Cells Important (and commonly problematic!) – Neutrophils – Lymphocytes u Important (less commonly problematic) – Monocytes – eosinophils u Less important u – basophils www. cambridgehaematology. com

Neutrophils www. cambridgehaematology. com

Neutrophilia u Often result ‘expected’ – History – Examination – primary haematological cause NOT common www. cambridgehaematology. com

Neutrophilia u Infection u Inflammation / necrosis u Cancer – any sort reported u Bone marrow disease (MPDs, CML) u Drugs (steroids!!, growth factors) Not always pathological Pregnancy, smoking, normal variant! www. cambridgehaematology. com

Neutropenia (<1. 5 x 109/l) Isolated neutropenia vs Pancytopenia www. cambridgehaematology. com

How worried should I be? u Pancytopenia is ALWAYS worrying u Many cases of isolated neutropenia are less serious u What should I do with a neutropenic patient? u How common is neutropenic sepsis? www. cambridgehaematology. com

Pancytopenia u Marrow Failure – Drugs (chemotherapy) – Infiltration (cancer, MF, lymphoma etc. ) – Myelodysplasia / leukaemia / myeloma – Aplastic anaemia / PNH – Don’t forget B 12 / folate (anorexia) u Peripheral consumption – hypersplenism www. cambridgehaematology. com

Pancytopenia u Referral usually required u Bone marrow biopsy usually required www. cambridgehaematology. com

Isolated Neutropenia Not always easy to identify a cause! u Always think drugs (idiopathic vs dose) u Viral infection u Auto-immune disease u Marrow causes u (sepsis / very ill elderly) u Don’t forget – Racial variation – cyclical neutropenia (clinical and lab details) – If child, think congenital www. cambridgehaematology. com

Isolated Neutropenia u Investigations presentation will depend on clinical – Chance finding vs ill patient – Viral serology may be indicated (hepatitis, EBV etc – Think HIV!) – Autoimmune (SLE, sjorgrens, RA – Felty’s) – Serial blood counts – Referral may be required www. cambridgehaematology. com

Isolated Neutropenia u When to refer urgently – Cause of neutropenia – Is the patient acutely ill? u Neutropenic fever vs sepsis – Incidence etc – Antibiotic policies etc. – Prophylactic antibiotics - controversial www. cambridgehaematology. com

Lymphocytes Lineage B vs T vs NK Origin Role www. cambridgehaematology. com

Lymphocytosis u Causes – Reactive (CMV, EBV, hepatitis, toxo, adenov) Pertussiss Inflammatory reaction (not common) – Lymphoproliferative disorder Acute and chronic leukaemias lymphomas www. cambridgehaematology. com

Lymphocytosis u Priorities for investigation – Clinical picture – If other FBC abnormalities, speak to a haematologist – If in doubt, ask for an opinion on a blood film – Monospot test vs viral serology – Flow cytometry – Molecular tests www. cambridgehaematology. com

Lymphocytosis (>4 x 109/l) vs u Blasts vs vs more mature cells u Clinical picture very important – Young sick child vs older well patient www. cambridgehaematology. com

Lymphocytosis u Young patient with clinical picture of infectious mononucleosis – Monospot useful – Film useful (rule out ALL) – Flow cytometry less helpful – Serology as second line investigation – ID referral occasionally required – (worth thinking about acute HIV) www. cambridgehaematology. com

Lymphocytosis u Acute lymphoblastic leukaemia – Children >> adults – Often presents very acutely – Range of clinical features – Laboratory features typical – Referral mandatory www. cambridgehaematology. com

Lymphocytosis u Older patient with lymphocytosis – Blood film required (CLL vs LGL) – Flow cytometry usually required – ? Refer u Clinical picture u Underlying diagnosis www. cambridgehaematology. com

Lymphocytosis u CLL – Relatively common (300 + / year) – New entity of Monoclonal B Lymphocytosis (MBL) – Age – Clinical presentation Asymptomatic stage A VS Symptomatic stage C www. cambridgehaematology. com

Lymphocytosis u CLL – History u Night sweats, weight loss, INFECTIONS – Examination u Lymphadenopathy, hepato-splenomegaly – Investigation u Flow cytometry www. cambridgehaematology. com

Lymphocytosis u Flow cytometry T cells Leukaemic B cells www. cambridgehaematology. com

Lymphocytosis u Should I refer CLL? – Long stage A phase in many patients – Patients and the ‘leukaemia’ word! – Rough guide u Symptomatic u Unusual / lymphoma phenotype u Lymphadenopathy / splenomegaly u Lymphocyte doubling time < 12 months with lymphocytes > 30 x 109/l u Hb < 10 g/dl (or haemolysing) u Platelets < 100 x 109/l www. cambridgehaematology. com

Lymphocytosis u CLL – beware – Not always benign – Infections (hypogamma) – Haemolysis – ITP www. cambridgehaematology. com

Lymphocytosis u Rarer lymphoproliferative disorders – LGL – PLL – Leukaemic phase of most lymphomas – Hairy cell leukaemia www. cambridgehaematology. com

Lymphopenia (<1. 0 x 109/l) u Many u How cases reflect normal variants hard should you chase a cause? u More common causes – HIV / hepatitis / Hodgkin’s (steroids) u Rarer causes – Autoimmune disease / sarcoidosis www. cambridgehaematology. com

Lymphopenia u Investigations – Clinical picture – Lymphocyte subset analysis – RARE – bone marrow www. cambridgehaematology. com

Enlarged LN ? cause u Clinical context is critical u Please do first line investigations – ? Symptom profile – (? spleen) – FBC may save a LN biopsy Neck nodes – ENT fast track referral u Axillary and groin nodes u – Much depends on the clinical context – Haematology review first? – Biopsy first? – CT first? www. cambridgehaematology. com

Eosinophils u High – Allergic disorders – Drug Hypersensitivity – Skin Diseases – Parasitic infections – Myeloproliferative disorders – Connective tissue disorders u Churg Strauss www. cambridgehaematology. com

Monocytes u High – Range of infectious and inflammatory stimuli – Primary BM conditions u CMML (overlap between myelodysplasia and myeloproliferative disorder) u CML Clinical picture and blood film important If no clear cause consider haematology referral www. cambridgehaematology. com

Questions? Cambridge Haematology Partners www. cambridgehaematology. com charles. crawley@cambridgehaematology. com george. follows@cambridgehaematology. com
- Slides: 84